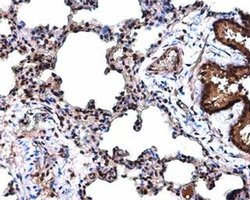
Cyclin D3 Polyclonal Antibody, Invitrogen 100 &mu;L; Unconjugated:Antibodies,

Learn More
Cyclin D3 Polyclonal Antibody, Invitrogen™
Rabbit Polyclonal Antibody
Supplier: Thermo Scientific PA577891
Description
Predicted Reactivity: Pig (97%), Sheep (99%), Rhesus Monkey (100%), Bovine (99%) Store product as a concentrated solution. Centrifuge briefly prior to opening the vial. For short-term storage (1-2 weeks), product can be stored at 4°C. For long-term storage, aliquot and store product at -20° C or below, avioiding multiple freeze-thaw cycles.
Cyclin D3 is a regulatory component of the cyclin D3-CDK4 (DC) complex that phosphorylates and inhibits members of the retinoblastoma (RB) protein family including RB1 and regulates the cell-cycle during G(1)/S transition. Phosphorylation of RB1 allows dissociation of the transcription factor E2F from the RB/E2F complex and the subsequent transcription of E2F target genes which are responsible for the progression through the G(1) phase. Hypophosphorylates RB1 in early G(1) phase. Cyclin D-CDK4 complexes are major integrators of various mitogenenic and antimitogenic signals. Also substrate for SMAD3, phosphorylating SMAD3 in a cell-cycle-dependent manner and repressing its transcriptional activity. Component of the ternary complex, cyclin D3/CDK4/CDKN1B, required for nuclear translocation and activity of the cyclin D-CDK4 complex.
Specifications
| Cyclin D3 | |
| Polyclonal | |
| Unconjugated | |
| CCND3 | |
| CCND3, G1/S-specific cyclin-D3, G1/S-specific cyclin D3, D3-type cyclin, cyclin D3 | |
| Rabbit | |
| Antigen affinity chromatography | |
| RUO | |
| 12445, 25193, 896 | |
| Store at 4°C short term. For long term storage, store at -20°C, avoiding freeze/thaw cycles. | |
| Liquid |
| Immunocytochemistry, Immunofluorescence, Immunohistochemistry (Paraffin), Western Blot | |
| 1 mg/ml | |
| PBS with 1% BSA, 20% glycerol and 0.01% thimerosal; pH 7 | |
| P30281, P30282, P48961 | |
| Ccnd3 | |
| Recombit protein encompassing a sequence within the center region of human Cyclin D3. The exact sequence is proprietary. | |
| 100 μL | |
| Primary | |
| Human, Mouse, Rat | |
| Antibody | |
| IgG |
Your input is important to us. Please complete this form to provide feedback related to the content on this product.